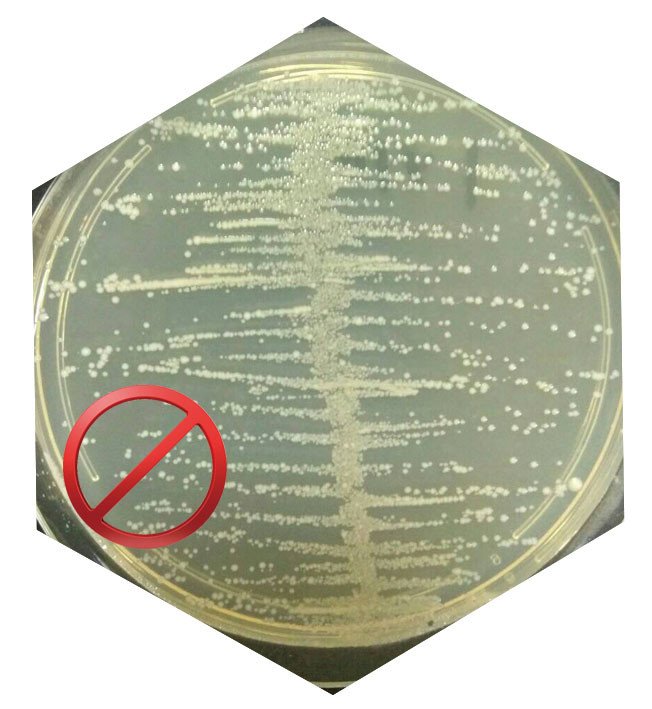

Aquaculture
Nano Silver Colloidal Product Description
—Advanced Silver ion Ag+ application in aquaculture
- Disease prevention:Wide-area for anti-virus/antibacteria。
- Disinfection prevention:bottom tank, water,tansport fish/shrimp。
- Water treatment:Control harmful algae, nitrite, improve water color。
- Delivery and Preservation:Aquatic may spoil and deteriorate in a short time。
- Added to the feed。
- No antibiotic residues:nanosilver use Low dose, long-acting。
AGNP CLEAN ~Ag+ Nano Silver Aqueous solution
Epidemic Prevention : Bacterial , Virus , Mold , Fungal , Deodorant .
Nano silver ion aqueous solution is very high concentration which gives greater efficiency and is more effective in killing more than 650 kinds of bacteria and virus.
AGNP CLEAN's nano silver colloidal solution product . It's already well dispersed, and easy to be applied. The content range we offer 10000ppm is the biggest choice for customer.
Comparing to traditional chemical medicine and antibiotics, AGNP CLEAN has no issues of drug resistance and residue in the body. It has been successfully used in aquaculture,agriculture,animal husbandry and environmental.

The demand for human animal protein continues to increase, and marine resources continue to be depleted. The main driving force for future fishery production is aquaculture. However, high-density farming and the extraction of contaminated surface seawater, in order to increase the breeding rate, cause the abuse of antibiotics, make the antibiotic residues in the water body extremely serious, and become a large dye tank for the cultivation of "resistant bacteria". The aquaculture industry is using different innovative technologies, such as metal nanoparticles-nano-silver wide-area antiviral and bacterial properties, which can be used to prevent diseases, disinfection, water treatment, transportation and preservation, etc.
White Spot Syndrome Virus (WSSV)

STREPTOCOCCOSIS

VIBRIO VULNIFICUS
Advanced application of silver ions in aquaculture to prevent diseases-Shrimp White spot syndrome virus (WSSV), Shrimp Early Mortality Syndrome ( EMS ), streptococcus fish; disinfection-can be combined with chlorine dioxide and BKC disinfection effect; water treatment improves water color; fish and shrimp transportation And preservation; added to the feed without antibiotic residues; low-dose nano-silver use, long-term inhibition of marine vibrio.
A. Disease prevention:
Instead of antibiotics, nanosilver can broadly resist viruses/bacteria/fungi.
How to use:
Category:Shrimp-Mycelium larvae to late larvae, to adult shrimp / shrimp ,Fish-fry to adult fish
Usage:0.2ml added to 1 ton of water (20ppb)
Frequency:
a. No water change, once every two weeks
b. Change the water
Note:
When the fish is sick, add: 6ml to 1 ton of water(60ppb)
Frequency: how much water is added in proportion
Adult fish surface ulcers caused by high vibrio counts and then death, the use of nano silver treatment can reduce the amount of vibrio and reduce losses. Nano silver will consume some probiotics, probiotic supplements (2-3 days later).
B. Prevention and disinfection:
Pond, make-up water, water in the pool, and environmental pollution prevention.
① Project:Fishpond cleaning and surface disinfection
Dosage:0.5mL/m2, spray the surface after dilution with 5PPM concentration. Natural drying does not require repeated washing, and the action time is 24 hours.
② Project:After the pond is cleaned. (Before the seedlings are released)
Dosage:2mL/m2, added to the pond water at a concentration of 20ppm. Kill pathogenic microorganisms in water and prevent the growth of microorganisms.
③ Project:daily maintenance
Dosage:0.2mL/m2, added to the pond water at a concentration of 20ppb. Once every two weeks.
With chlorine dioxide disinfection effect is better:
First remove non-resistant bacteria in the fish pond with chlorine dioxide for 12 to 24 hours, and then add 0.2ml/ton of nano-silver to prevent and control resistant bacteria for a long time.
C. Water quality treatment:
Control harmful algae, reduce the concentration of harmful factors such as nitrite, and improve water color
How to use:
The disinfectant itself is also a kind of water environment improver. The main component of Yinnajing is nano silver ions with high concentration. Its bactericidal performance is much higher than common chlorine, quaternary ammonium salt, simple hydrogen peroxide, aldehyde and other disinfectants .
D. Aquatic Delivery and preservation:
Aquatic products such as fish and shrimp may spoil and deteriorate in a short time by the action of amino acid enzymes in the body.
How to use:
① Category:Shrimp/Fry Delivery
Usage:2.5 ml added to 1 ton of water (25ppb)
Frequency:single
② Category:fish delivery
Usage:5 ml added to 1 ton of water (50ppb)
Frequency:single
E. Added to the feed:
The feed formula is highly efficient, environmentally friendly, healthy, and antibiotic-free feed is the future trend.
How to use:
First mix it with 5-10 liters of water, and then mix it with the feed by spraying.
① General prevention:
Dosage:Add 500 ml per ton of feed.
Frequency:Feed 1~2 days a week (please feed each meal)
②Symptoms:
Dosage:Add 1000-2500 ml per ton of feed.
Frequency:Each meal is fed until the epidemic is stable, and then changed back to the normal preventive concentration.
F. Without antibiotics:
Nano-silver uses a low dose, it can be long-acting antibacterial and non-resistant.
NOTE1 : Probiotics supplement (after 2-3 days): Nano silver will consume some probiotics.
NOTE2: Water disinfection effect is better:
First remove the non-resistant bacteria in the fish pond with chlorine dioxide for 12 ~ 24 hours, then add nano silver 0.2ml / ton to prevent and control the resistant bacteria for a long time.
Aquaculture Bacteria
Aquaculture common seen bacteria and related symptoms in below chart.
Pathogenic Bacteria | ||
Epidemic prevention :
AGNP CLEAN ~Nano Silver Aqueous solution has good epidemic prevention the following bacteria, virus and diseases of aquaculture.

Shrimp
★White Spot Syndrome Virus (WSSV)
★ Syndrome Virus (TSV)
★Early Mortality Syndrome (EMS)
★ monodon-type baculovirus (MBV)
★Cramp Tail Syndrome(CMS)
★Infectious Myonecrosis Virus (IMNV)
★Yellow Vibrio
★ hepatopenaei (EHP)
★ Hepatopancreatitis (NHP)
★ Virus (YHV)
★Infectious Hypodermal and Hematopoietic Necrosis
Virus(IHHNV)

Fish
★Nuka bacteria
★Edwards disease
★Various Vibriosis
★Yellow liver disease
★Enterogenous necrosis virus
★Rainbow virus
★Muscle perforation
★Red envelope virus
★Streptococcal disease
★White spot disease
★Fungal infection
Antimicrobial Test
Antimicrobial Effectiveness Testing
Organism: Staphylococcus aureus
 |  |  |
Staphylococcus aureusOriginal Inoculum 3.1x 105(CFU/mL) | add AGNPCLEAN 20ppbContact time : 60min Anti Micro Activity(%) >99 | add AGNPCLEAN 20ppbContact time: 24HR Anti Micro Activity(%) >99.9 |